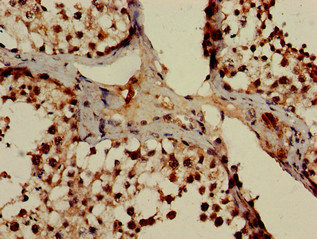

POT1 Antibody
-
中文名稱:POT1兔多克隆抗體
-
貨號:CSB-PA868326LA01HU
-
規格:¥440
-
圖片:
-
Immunohistochemistry of paraffin-embedded human skeletal muscle tissue using CSB-PA868326LA01HU at dilution of 1:100
-
Immunohistochemistry of paraffin-embedded human testis tissue using CSB-PA868326LA01HU at dilution of 1:100
-
Immunofluorescent analysis of Hela cells using CSB-PA868326LA01HU at dilution of 1:100 and Alexa Fluor 488-congugated AffiniPure Goat Anti-Rabbit IgG(H+L)
-
-
其他:
產品詳情
-
產品描述:
Immunization of rabbits with the peptide mapping within amino acids 250-432 of the human protection of telomere protein 1 (POT1) and subsequent protein G-mediated purification from the resulting anti-serum lead to the production of the POT1 antibody. This POT1 antibody is a polyclonal antibody and exists as an unconjugated IgG. Its purity is over 95%. It only reacts with human POT1 protein. Validations of this antibody in ELISA, IHC, and IF have been tested. The target protein POT1, an essential subunit of the shelterin telomere binding complex, protects chromosomal ends from an inappropriate DNA damage response by directly binding to single-stranded telomeric DNA. It plays a role in telomere length regulation.
-
產品名稱:Rabbit anti-Homo sapiens (Human) POT1 Polyclonal antibody
-
Uniprot No.:
-
基因名:
-
別名:DKFZP586D211 antibody; hPot 1 antibody; hPot1 antibody; POT 1 antibody; POT1 antibody; POT1 like telomere end-binding protein antibody; POT1 protection of telomeres 1 homolog antibody; POT1-like telomere end-binding protein antibody; POTE1_HUMAN antibody; Protection of telomeres 1 antibody; Protection of telomeres 1 homolog (S. pombe) antibody; Protection of telomeres protein 1 antibody
-
宿主:Rabbit
-
反應種屬:Human
-
免疫原:Recombinant Human Protection of telomeres protein 1 protein (250-432AA)
-
免疫原種屬:Homo sapiens (Human)
-
標記方式:Non-conjugated
本頁面中的產品,POT1 Antibody (CSB-PA868326LA01HU),的標記方式是Non-conjugated。對于POT1 Antibody,我們還提供其他標記。見下表:
-
克隆類型:Polyclonal
-
抗體亞型:IgG
-
純化方式:>95%, Protein G purified
-
濃度:It differs from different batches. Please contact us to confirm it.
-
保存緩沖液:Preservative: 0.03% Proclin 300
Constituents: 50% Glycerol, 0.01M PBS, pH 7.4 -
產品提供形式:Liquid
-
應用范圍:ELISA, IHC, IF
-
推薦稀釋比:
Application Recommended Dilution IHC 1:20-1:200 IF 1:50-1:200 -
Protocols:
-
儲存條件:Upon receipt, store at -20°C or -80°C. Avoid repeated freeze.
-
貨期:Basically, we can dispatch the products out in 1-3 working days after receiving your orders. Delivery time maybe differs from different purchasing way or location, please kindly consult your local distributors for specific delivery time.
-
用途:For Research Use Only. Not for use in diagnostic or therapeutic procedures.
相關產品
靶點詳情
-
功能:Component of the telomerase ribonucleoprotein (RNP) complex that is essential for the replication of chromosome termini. Is a component of the double-stranded telomeric DNA-binding TRF1 complex which is involved in the regulation of telomere length by cis-inhibition of telomerase. Also acts as a single-stranded telomeric DNA-binding protein and thus may act as a downstream effector of the TRF1 complex and may transduce information about telomere maintenance and/or length to the telomere terminus. Component of the shelterin complex (telosome) that is involved in the regulation of telomere length and protection. Shelterin associates with arrays of double-stranded TTAGGG repeats added by telomerase and protects chromosome ends; without its protective activity, telomeres are no longer hidden from the DNA damage surveillance and chromosome ends are inappropriately processed by DNA repair pathways. Binds to two or more telomeric single-stranded 5'-TTAGGG-3' repeats (G-strand) and with high specificity to a minimal telomeric single-stranded 5'-TAGGGTTAG-3' sequence. Binds telomeric single-stranded sequences internally or at proximity of a 3'-end. Its activity is TERT dependent but it does not increase TERT activity by itself. In contrast, the ACD-POT1 heterodimer enhances telomere elongation by increasing telomerase processivity.
-
基因功能參考文獻:
- POT1 was identified at 70 kDa in biopsy tissue of cervical cancer patients and its level was higher than that in normal cervical smears; the high level of POT1 in the biopsy tissue of cervical cancer patients showed the influence of this shelterin component in cervical carcinogenesis and also cell immortalization PMID: 28425274
- A defective POT1-TPP1 complex leads to longer and fragile telomeres, which in turn promotes genomic instability and cancer. PMID: 28393830
- several missense mutations in human cancers that disrupt the POT1C-TPP1 interaction, resulting in POT1 instability, were identified. PMID: 28393832
- melanoma associated POT1 germline variants seem to be rare. PMID: 29523635
- Results indicate that lenti-shRNA-mediated POT1-KD significantly reduced POT1 mRNA and protein expression. POT1-KD immediately downregulated c-Myc expression, which led to the inhibition of cell proliferation, tumorigenesis, and HDACi response PMID: 29546066
- A role of POT1 germline mutations in cancer predisposition beyond melanoma development PMID: 28389767
- study suggests that, gallstone does not affect telomere length and even after having increased telomere length, decreased expression of some shelterin genes in inflamed tissue might cause telomeres to cap improperly, possibly leading to telomere dysfunction and further, gallbladder carcinogenesis PMID: 28643740
- loss-of-function mutations in protection of telomeres 1 (POT1) co-segregated with Chronic lymphocytic leukemia. PMID: 27528712
- hPOT1 OB-folds are required to protect and prevent newly replicated telomeres from engaging in Alternative non-homologous end joining mediated fusions that would otherwise promote genome instability to fuel tumorigenesis. PMID: 27869160
- the study identifies mutations in KRAS and POT1 as novel determinants of outcome after chemoimmunotherapy using chlorambucil and anti-CD20 treatment. PMID: 27226433
- Binding of POT1-TPP1 unfolds telomere secondary structure to assist loading of additional heterodimers. PMID: 27173378
- Coats plus is caused by a defect in POT1/CST-dependent telomere fill-in PMID: 27013236
- Downregulation of Protection of Telomeres 1 expression in myelodysplastic syndromes with 7q deletion. PMID: 26105212
- The conservation between fission yeast Tpz1-Pot1 and human TPP1-POT1 interactions resulted in mapping a human melanoma-associated POT1 mutation (A532P) to the TPP1-POT1 interface. PMID: 26365187
- Missense variant p.R117C is associated with cardiac angiosarcoma in TP-53 negative Li-Fraumeni-like families. Mutation carriers show reduced telomere-bound POT1 levels, abnormally long telomeres and increased telomere fragility. PMID: 26403419
- OB-fold domain 1 of human POT1 recognizes both telomeric and non-telomeric DNA motifs PMID: 25934589
- these data provide a molecular basis by which POT1-TPP1 increases the processivity of telomerase15. Further, we show that this increased processivity may arise from the dynamic sliding of POT1-TPP1 that induces fast translocation of telomerase. PMID: 25263700
- The clinicopathological findings differed in the expression of hPOT1. PMID: 25194444
- Expression of shelterin component POT1 is associated with decreased telomere length and immunity condition in humans with severe aplastic anemia. PMID: 24892036
- TMPyP4 (meso-tetra(N-methyl-4-pyridyl)porphine) has been widely used as G-quadruplex binding ligand, which stabilized the G-quadruplex in vitro and in cellulo, resulting in down-regulation of pot1 gene transcription. PMID: 24631651
- the participation of POT1 in the transformation process from MGUS to MM, and provide evidence of this gene as a useful prognostic factor in MM as well as a possible molecular target to design new therapeutic strategies. PMID: 24239198
- Rare missense variants in POT1 predispose to familial cutaneous malignant melanoma. PMID: 24686846
- POT1 loss-of-function variants predispose to melanoma formation via a direct effect on telomeres. PMID: 24686849
- study found POT1 exists in at least 3 forms;90,70 and 45kD;abundance of the POT1 forms can be altered by modulation of POT1 nuclear localization; evidence that there are posttranslational modifications of POT1 that can affect its molecular weight, intracellular localization and function PMID: 24054699
- G-quadruplex formation of telomeres significantly enhances the ability of POT1/TPP1 to block RPA's access to telomeres. PMID: 24516170
- POT1-TPP1 binds telomeric DNA in a coordinated manner to facilitate assembly of the nucleoprotein complexes into a state that is more accessible to enzymatic activity. PMID: 23616058
- Gene variation of pot1 Exon14 is associated with endometrial cancer PMID: 23317234
- POT1 mutations cause telomere dysfunction and is associated with chronic lymphocytic leukemia. PMID: 23502782
- The POT1 stimulates the binding and enzymatic activities of the LP-BER proteins APE1, FEN1 and LigI both individually and when they act together in reconstituted LP-BER using a telomeric substrate. PMID: 22336916
- The effects of hPOT1 RNAi seem to be functionally linked to up-regulation of PinX1 and down-regulation of hTERT. PMID: 21778296
- Mouse gene deletion experiments revealed DNA-damage-response pathways that threaten chromosome ends and how the components of the telomeric shelterin complex prevent activation of these pathways.[Shelterin] PMID: 21209389
- These results suggest that FOXP2 is a binding partner for the nuclear translocation of POT1. PMID: 21684252
- The human POT1-TPP1 complex is a processivity factor for telomerase. PMID: 21461822
- telomeric tails rarely form the maximum potential number of G4 units provides a structural basis for the coexistence of G4 and POT1 on the same DNA molecule PMID: 21183684
- data suggest that hnRNPA1, TERRA and POT1 act in concert to displace RPA from telomeric ssDNA after DNA replication, and promote telomere capping to preserve genomic integrity PMID: 21399625
- the protein network surrounding telomere repeat binding factors, TRF1, TRF2, and POT1 using dual-tag affinity purification PMID: 20811636
- Results support a model in which POT1-TPP1 enhances telomerase processivity in a manner markedly different from the sliding clamps used by DNA polymerases. PMID: 20094033
- Four single nucleotide polymorphisms in the TERT and POT1 genes were significantly related with overall breast cancer risk. PMID: 20056641
- Data support RPA enhancement of branch migration during homologous recombination repair and, conversely, POT1 limitation of inappropriate recombination and branch migration at telomeric ends. PMID: 19812417
- Data show that epitope-tagged human protection of telomeres protein (Pot1) localizes to telomeres in interphase nuclei of human cells, consistent with a direct role in telomere end protection. PMID: 12391173
- the interaction between the TRF1 complex and POT1 affects the loading of POT1 on the single-stranded telomeric DNA, thus transmitting information about telomere length to the telomere terminus, where telomerase is regulated PMID: 12768206
- hPOT1 can act as a telomerase-dependent, positive regulator of telomere length PMID: 12781132
- POT1 has a strong sequence preference for the human telomeric repeat tract and can bind both the 3' telomeric overhang and the displaced TTAGGG repeats at the base of the t-loop PMID: 14715659
- Changes in POT1 expression levels may be associated with stomach carcinogenesis and progression. PMID: 14744765
- Data show that a DAT domain mutant of hTERT is efficiently rescued upon fusion to hPot1. PMID: 15060173
- PTOP heterodimerizes with POT1 and regulates POT1 telomeric recruitment and telomere length. PMID: 15181449
- crystal structure at a resolution of 1.73 A of the N-terminal half of human POT1 (hPOT1) protein bound to a telomeric single-stranded DNA (ssDNA) decamer, TTAGGGTTAG, the minimum tight-binding sequence indicated by in vitro binding assays PMID: 15558049
- Pot1 protects chromosome ends from illegitimate recombination, catastrophic chromosome instability, and abnormal chromosome segregation. PMID: 15620654
- Data show that protection of telomeres 1 (POT1) negatively affects telomerase activity in vitro, and that the DNA binding activity of POT1 is required for telomerase inhibition. PMID: 15632080
- The reduction of POT1 by RNA interference led to the loss of telomeric single-stranded overhangs and induced apoptosis, chromosomal instability, and senescence in cells. PMID: 15657433
顯示更多
收起更多
-
相關疾病:Melanoma, cutaneous malignant 10 (CMM10); Glioma 9 (GLM9)
-
亞細胞定位:Nucleus. Chromosome, telomere. Note=Colocalizes with telomeric DNA.
-
蛋白家族:Telombin family
-
組織特異性:Ubiquitous.
-
數據庫鏈接:
Most popular with customers
-
-
YWHAB Recombinant Monoclonal Antibody
Applications: ELISA, WB, IHC, IF, FC
Species Reactivity: Human, Mouse, Rat
-
-
-
-
-
-